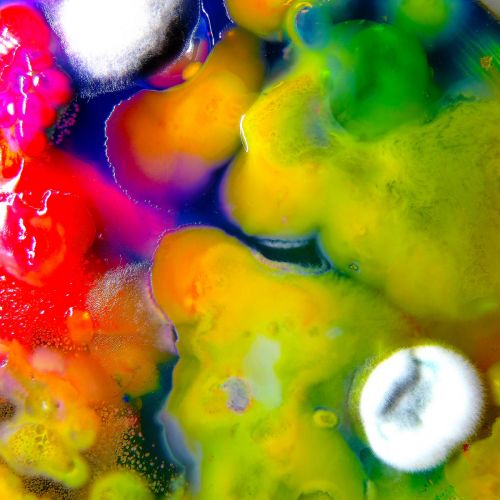

Additional information
| Weight | 0.74 lbs |
|---|---|
| Format | LP Records |
$24.99
Ltd. first press on transparent-purple vinyl Famously Alive finds Guerilla Toss coming into the fullness of their power, celebrating their prismatic idiosyncrasies from a place of optimism and abundance.
In stock
| Weight | 0.74 lbs |
|---|---|
| Format | LP Records |